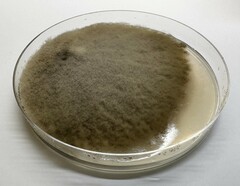
Alternaria alstroemeriae
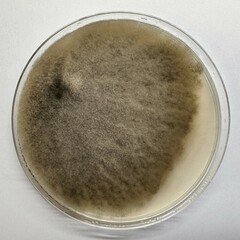
Alternaria alstroemeriae
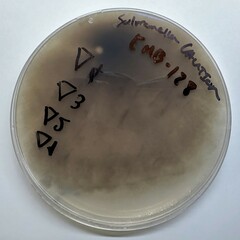
Alternaria alstroemeriae
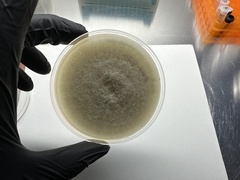
Alternaria alstroemeriae
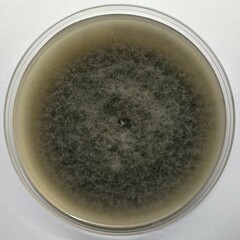
Alternaria alstroemeriae

Alternaria alstroemeriae: taxon details and analytics
- Domain
- Kingdom
- Fungi
- Phylum
- Ascomycota
- Class
- Dothideomycetes
- Order
- Pleosporales
- Family
- Pleosporaceae
- Genus
- Alternaria
- Species
- Alternaria alstroemeriae
- Scientific Name
- Alternaria alstroemeriae
Images from inaturalist.org observations:
We recommend you sign up for this excellent, free service.
Parent Taxon
Sibling Taxa
- Acroconidiella eschscholziae
- Alternaria abundans
- Alternaria alstroemeriae
- Alternaria alternantherae
- Alternaria alternariae
- Alternaria alternata
- Alternaria amaranthi
- Alternaria anagallidis
- Alternaria angustiovoide
- Alternaria arborescens
- Alternaria arbusti
- Alternaria argyranthemi
- Alternaria atra
- Alternaria bornmuelleri
- Alternaria botryospora
- Alternaria botrytis
- Alternaria brassicae
- Alternaria brassicicola
- Alternaria calendulae
- Alternaria calycanthi
- Alternaria carthami
- Alternaria catalpae
- Alternaria caudata
- Alternaria chartarum
- Alternaria cheiranthi
- Alternaria chlamydospora
- Alternaria chlamydosporigena
- Alternaria cinerariae
- Alternaria cinerea
- Alternaria citri
- Alternaria consortialis
- Alternaria cookei
- Alternaria crassa
- Alternaria cucumerina
- Alternaria cucurbitae
- Alternaria culmorum
- Alternaria cyphomandrae
- Alternaria danida
- Alternaria dauci
- Alternaria dianthi
- Alternaria dianthicola
- Alternaria dichondrae
- Alternaria echinaceae
- Alternaria embellisia
- Alternaria fulva
- Alternaria gaisen
- Alternaria gomphrenae
- Alternaria grossulariae
- Alternaria infectoria
- Alternaria japonica
- Alternaria jasmini
- Alternaria leptinellae
- Alternaria linicola
- Alternaria longipes
- Alternaria longissima
- Alternaria macrospora
- Alternaria mali
- Alternaria malorum
- Alternaria melongenae
- Alternaria mouchaccae
- Alternaria nelumbii
- Alternaria nobilis
- Alternaria obtecta
- Alternaria obtusa
- Alternaria oudemansii
- Alternaria oxytropis
- Alternaria padwickii
- Alternaria panax
- Alternaria papavericola
- Alternaria passiflorae
- Alternaria penicillata
- Alternaria phragmospora
- Alternaria porri
- Alternaria radicina
- Alternaria ramulosa
- Alternaria raphani
- Alternaria saponariae
- Alternaria scirpicola
- Alternaria scrophulariae
- Alternaria selini
- Alternaria solani
- Alternaria solani-nigri
- Alternaria sonchi
- Alternaria tabacina
- Alternaria tenuis
- Alternaria tenuissima
- Alternaria terricola
- Alternaria thunbergiae
- Alternaria tomato
- Alternaria triticina
- Alternaria viburni
- Alternaria violae
- Alternaria zinniae
- Macrosporium asimini
- Macrosporium dianthemphus
- Macrosporium stilbosporoideum
- Rhopalidium cercosporelloides